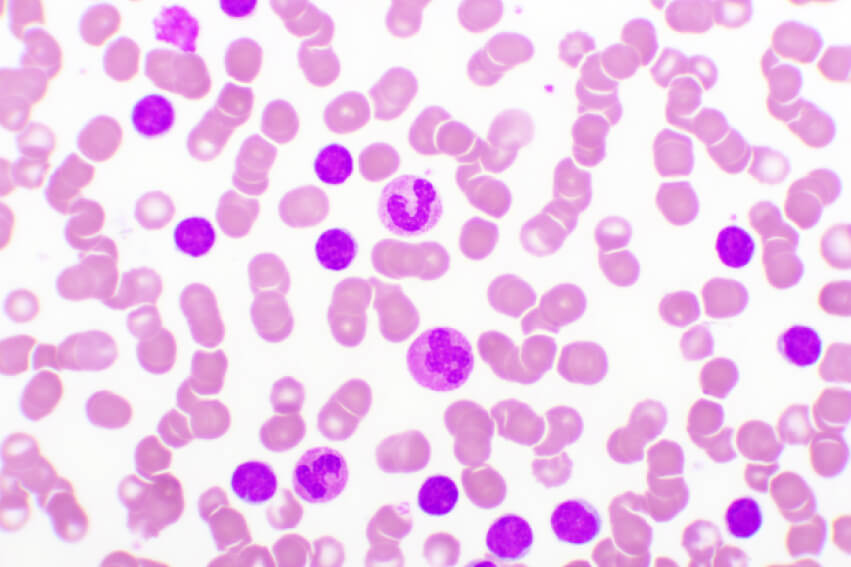

Die neusten Beiträge

Zielgerichtete Therapie mit BCL2-Inhibitor Venetoclax

🔒 Therapie der CML: Balance zwischen Wirksamkeit und Lebensqualität

CLL und SLL: Bessere Überlebenschancen mit Statinen?

Darmmikrobiom, Fettsäuren und Immunologie bei CLL

Vegane Ernährung bei chronisch lymphatischer Leukämie

COVID-19 und Acalabrutinib-Venetoclax: Auswirkungen auf CLL-Betroffene

🔒 CLL: Zulassungserweiterung für Pirtobrutinib empfohlen

S3-Leitlinie zur CLL in aktualisierter Version
CLL: Venetoclax-Kombinationen bei fitten Patienten schon in der Erstlinie einsetzen
